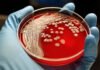
Enfermedades ya erradicadas podrían regresar a Venezuela debido a la baja cobertura de vacunación Enfermedades ya erradicadas podrían regresar a Venezuela debido a la baja cobertura de vacunación - thefreedompost.net

Dos personas resultaron heridas luego de que un funcionario del Cuerpo de Investigaciones Científicas, Penales y Criminalísticas (Cicpc) accionara su arma en su contra en medio de una discusión generada por un ataque de celos.

La trágica situación se registró el pasado domingo 17 de diciembre cuando una de las víctimas identificada como Alexander Rodríguez se encontraba celebrando su cumpleaños en en el piso 6 del edificio Briceño, en Delicia a San Fancisquito, en el centro de Caracas. A la reunión asistió su hija de 14 años identificada como Sofía Rodríguez quien también resultó herida en medio de la disputa, según informó el reportero Román Camacho a través de su cuenta en X.
Trascendió que durante la fiesta la mamá de la menor y expareja de Rodríguez se apersonó al compartir y todo transcurrió en sana paz, hasta que el funcionario del Cicpc y actual pareja de la progenitora se enteró que esta estaba en casa de su ex, lo que le generó tal molestia al uniformado que decidió asistir a la fiesta sin ser invitado.
Al llegar se generó una discusión entre el funcionario identificado como Ronny Viña (28) y Alexander Rodríguez, lo que provocó que Viña sacara su arma de fuego y la accionara en contra de la cara de Rodríguez, hiriéndolo en el pómulo. Desafortunadamente el disparo también alcanzó a Sofía Rodríguez quien resultó con una herida en la cabeza.
Ambos heridos, padre e hija, fueron trasladados al hospital Dr. Miguel Pérez Carreño donde fueron intervenidos quirúrgicamente. Alexander Rodríguez se encuentra estable, mientras que Sofía Rodríguez tiene un diagnóstico reservado. Ronny Viña hasta el momento está siendo buscado por las autoridades ya que huyó del sitio.
Esta y otras noticias en nuestro canal de Telegram TFPOficial; siguenos tambien por Instagram thefreedompost_